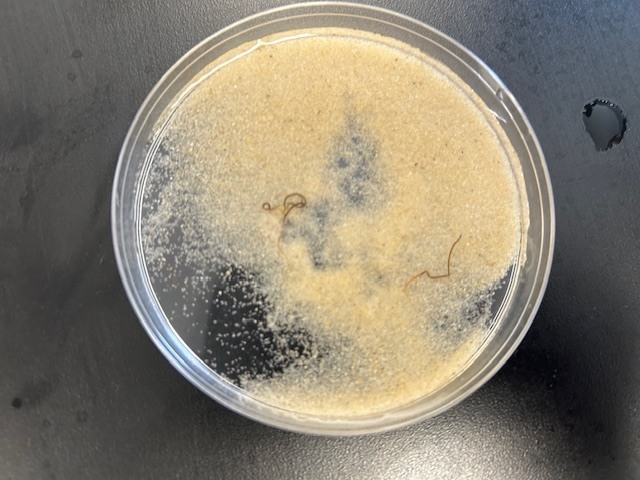
d

6th and 7th grade students will be participating in a vision screening on Wednesday, April 22nd. Please view the link below for information about Vision To Learn, frequently asked questions, and opt out forms. The opt out forms were passed out today. Please sign and return them to school next week if you DO NOT want your child to participate.
https://drive.google.com/drive/folders/18i2quoC1Bsg0lpyI5ApfgkoWgdJN0aR_?usp=sharing
https://drive.google.com/drive/folders/18i2quoC1Bsg0lpyI5ApfgkoWgdJN0aR_?usp=sharing

Fishing Team Interest Meeting

We hope you can join us on May 8th to see the Florence Chapel Singers perform the National Anthem at the Spartanburgers baseball game! Use the QR code to purchase tickets until April 24th.

Mr.Ebaugh's 7th grade science students conducted a hands-on lab investigation to answer the question: What are the important non-living characteristics of a habitat? From there, they took it a step further by designing their own experiments to determine which materials create the best habitat for black worms. 🪱

Tonight is the D5 Honor Band concert at 6:30 PM in the FAC. If you're unavailable to come in person but feel led to watch a livestream the link is below.
This group is composed of an equal number of students from all 4 middle schools. This was created to give students who didn't make region band or all-state band to have a clinic experience with a guest conductor. Follow the link below!
https://vimeo.com/event/5867343
This group is composed of an equal number of students from all 4 middle schools. This was created to give students who didn't make region band or all-state band to have a clinic experience with a guest conductor. Follow the link below!
https://vimeo.com/event/5867343


Tickets went on sale today! We hope to see you there on Friday!

Sports Physical Day is coming up! You must turn in the required forms and register your athlete here: https://students.arbitersports.com/organizations/florence-chapel-middle-school

The 8th Grade Dance is here!
***Friday, April 17th***
A night to dress your best, make memories, and say goodbye to Florence Chapel, friends, and teachers. Tickets will go on sale AFTER spring break. See you on the red carpet!
***Friday, April 17th***
A night to dress your best, make memories, and say goodbye to Florence Chapel, friends, and teachers. Tickets will go on sale AFTER spring break. See you on the red carpet!



BIG Congratulations to the 7th and 8th Grade Florence Chapel Singers on their Superior With Distinction!! We are so proud!

The Byrnes HS Girls Wrestling team is starting off season practice! This will be open to 7th-12th grade students. No experience necessary. Girls wrestle too!

Volunteers are still needed for the House Olympiad on April 3rd!
Links to sign up here: https://docs.google.com/forms/d/e/1FAIpQLScaOAQ0XRn-45d1x2EYaeg8K7nvSKq1higX-ZxJGjN0_-W2mg/viewform?usp=sharing&ouid=116655780573683235417
https://www.spart5.net/page/volunteers

I-Ready Diagnostics started today! Parents and students please remember to charge your computer at night and bring your charger to school.

March Madness… but make it geography 🌍🏀
Mrs. Howard’s students created their own brackets based on global data, predicting outcomes using latitude, population, land area, and currency value compared to the U.S. dollar. The real competition came with fact-checking their latitude bracket using atlases and seeing who comes out on top!






BIG congratulations to both the 7th and 8th grade bands for earning a Superior with Distinction at Concert Performance Assessment. Superior with Distinction is the highest possible rating a band can receive. This is a testament to their hard work and dedication. We are so proud of their accomplishments! 👏


We'd like to give a BIG THANK YOU to all of the vendors participating in the 7th Grade Career Fair on Friday! Our 7th graders are super excited!

After reading White Fur Flying, our RISE class brought the story to life!📚🐾 They had the special chance to meet a real Great Pyrenees named Max. Max worked very hard earning lots of pets and treats from our students.




Volunteer for the House Olympiad on April 3rd! There are different time slots available!
Sign up here: https://docs.google.com/forms/d/e/1FAIpQLScaOAQ0XRn-45d1x2EYaeg8K7nvSKq1higX-ZxJGjN0_-W2mg/viewform?usp=sharing&ouid=116655780573683235417
Be sure to fill out the District 5 Volunteer Form here:
https://www.spart5.net/page/volunteers

Rion Blikle spent Job Shadowing Day learning from the best at the Pelham-Batesville Fire Department alongside his dad, Robert Blikle! 🚒
Thank you to the Blikle family and the firefighters for giving Rion a firsthand look at what it takes to serve and protect the community.
We’re excited that the Pelham-Batesville Fire Department will also be joining us at the 7th Grade Career Fair at Abner Creek Middle on March 20th!
Thank you to the Blikle family and the firefighters for giving Rion a firsthand look at what it takes to serve and protect the community.
We’re excited that the Pelham-Batesville Fire Department will also be joining us at the 7th Grade Career Fair at Abner Creek Middle on March 20th!




Congratulations to the FCMS orchestra on their CPA rating! Superior With Distinction. We are so proud!


Upcoming SC Ready testing dates!

